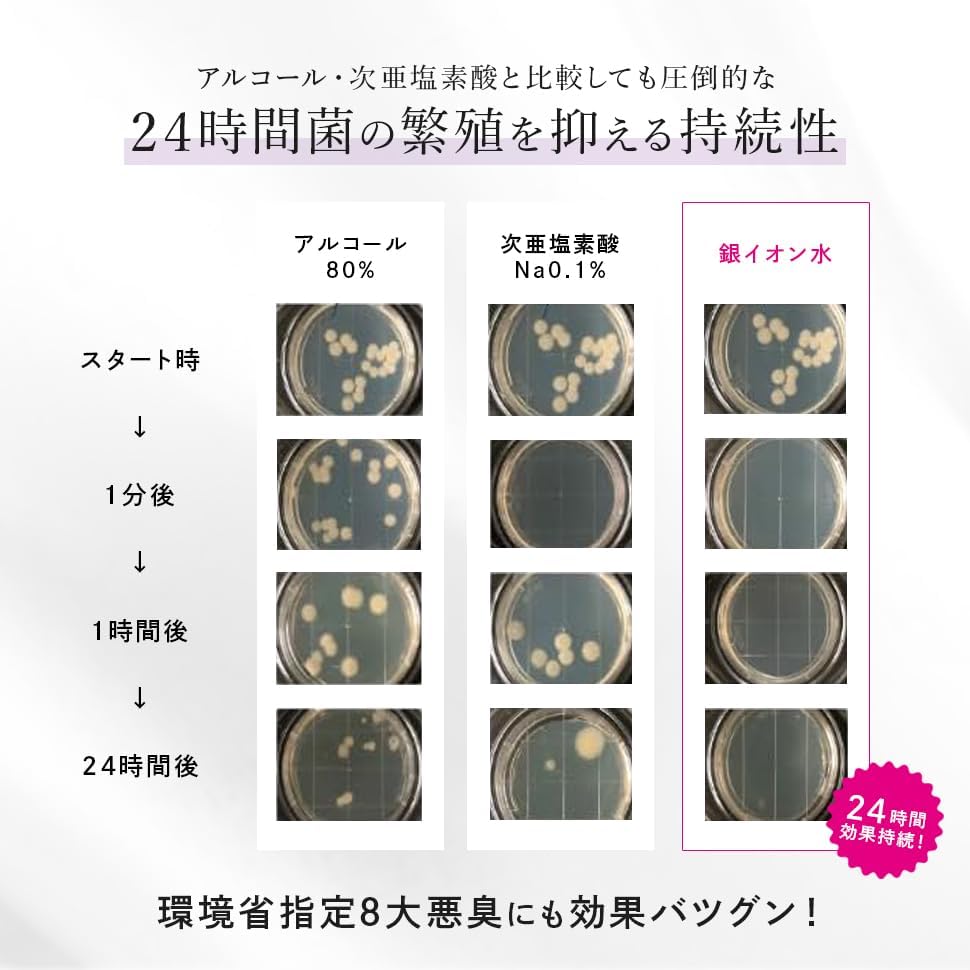

1/9
mögen. 除菌スプレー 銀イオン水 消臭・抗菌 化学薬品無添加 日本製 アルコールフリー 無臭 (【まとめ割】300ml2本+20mlカード型)
¥7,130
残り1点
International shipping available
* ◎【消臭・除菌・抗菌・花粉ブロック】除菌99.9%! これ1本であらゆるシーンに。カビ予防にも
* ◎【厚生労働省が定義】食品・食品添加物といわれる成分だけで作られているので飲めるほど安全
* ◎【銀イオン濃度が120倍】0.05ppmから効果があると認められている中、本製品は6ppmと高濃度
* ◎【化学薬品無添加】成分は99.99%純銀、純水、リンゴ酸のみ。化学薬品は一切使っていないので繊細体質さんも安心
* ◎【安心の国産&特許製法】安心安全の特許製法。赤ちゃんやペットがいる部屋でも安心(本製品は無臭です)
* ◎【二度拭き不要】ベタベタしないのでお掃除も楽ちん
* ◎カード型スプレーの色は選べません
最近チェックした商品
その他の商品